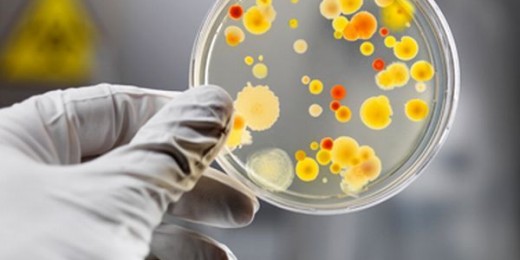
В Алуште выявлены факты сальмонеллеза

В Алуште на минувшей неделе выявлено три факта сальмонеллеза, подтвержденные лабораторными исследованиями. Об этом в ходе аппаратного совещания 19 августа сообщила инфекционист Алуштинской СЭС Зарема Рамазанова.
По ее словам, при этом общее число инфекционных заболеваний меньше, чем на аналогичный период прошлого года. На прошлой неделе в Алуштинском регионе зарегистрировано 40 случаев острых кишечных инфекций, это на 13% ниже, чем за аналогичный период 2013 года. «Из общего количества заболевших 85% – это дети. Кроме того, в общем числе инфекций отмечено три факта сальмонеллеза, подтвержденных лабораторными исследованиями. Также отмечено два случая ветряной оспы у детей и один факт заболевания вирусным гепатитом», – проинформировала Зарема Рамазанова.
Среди основных факторов, вызывающих острые кишечные инфекции на этой неделе в Алуште – пищевой (эту причину называют 55% заболевших), контактный путь передачи, низкая санитарная культура (25%) и качество морской воды (около 20%).
